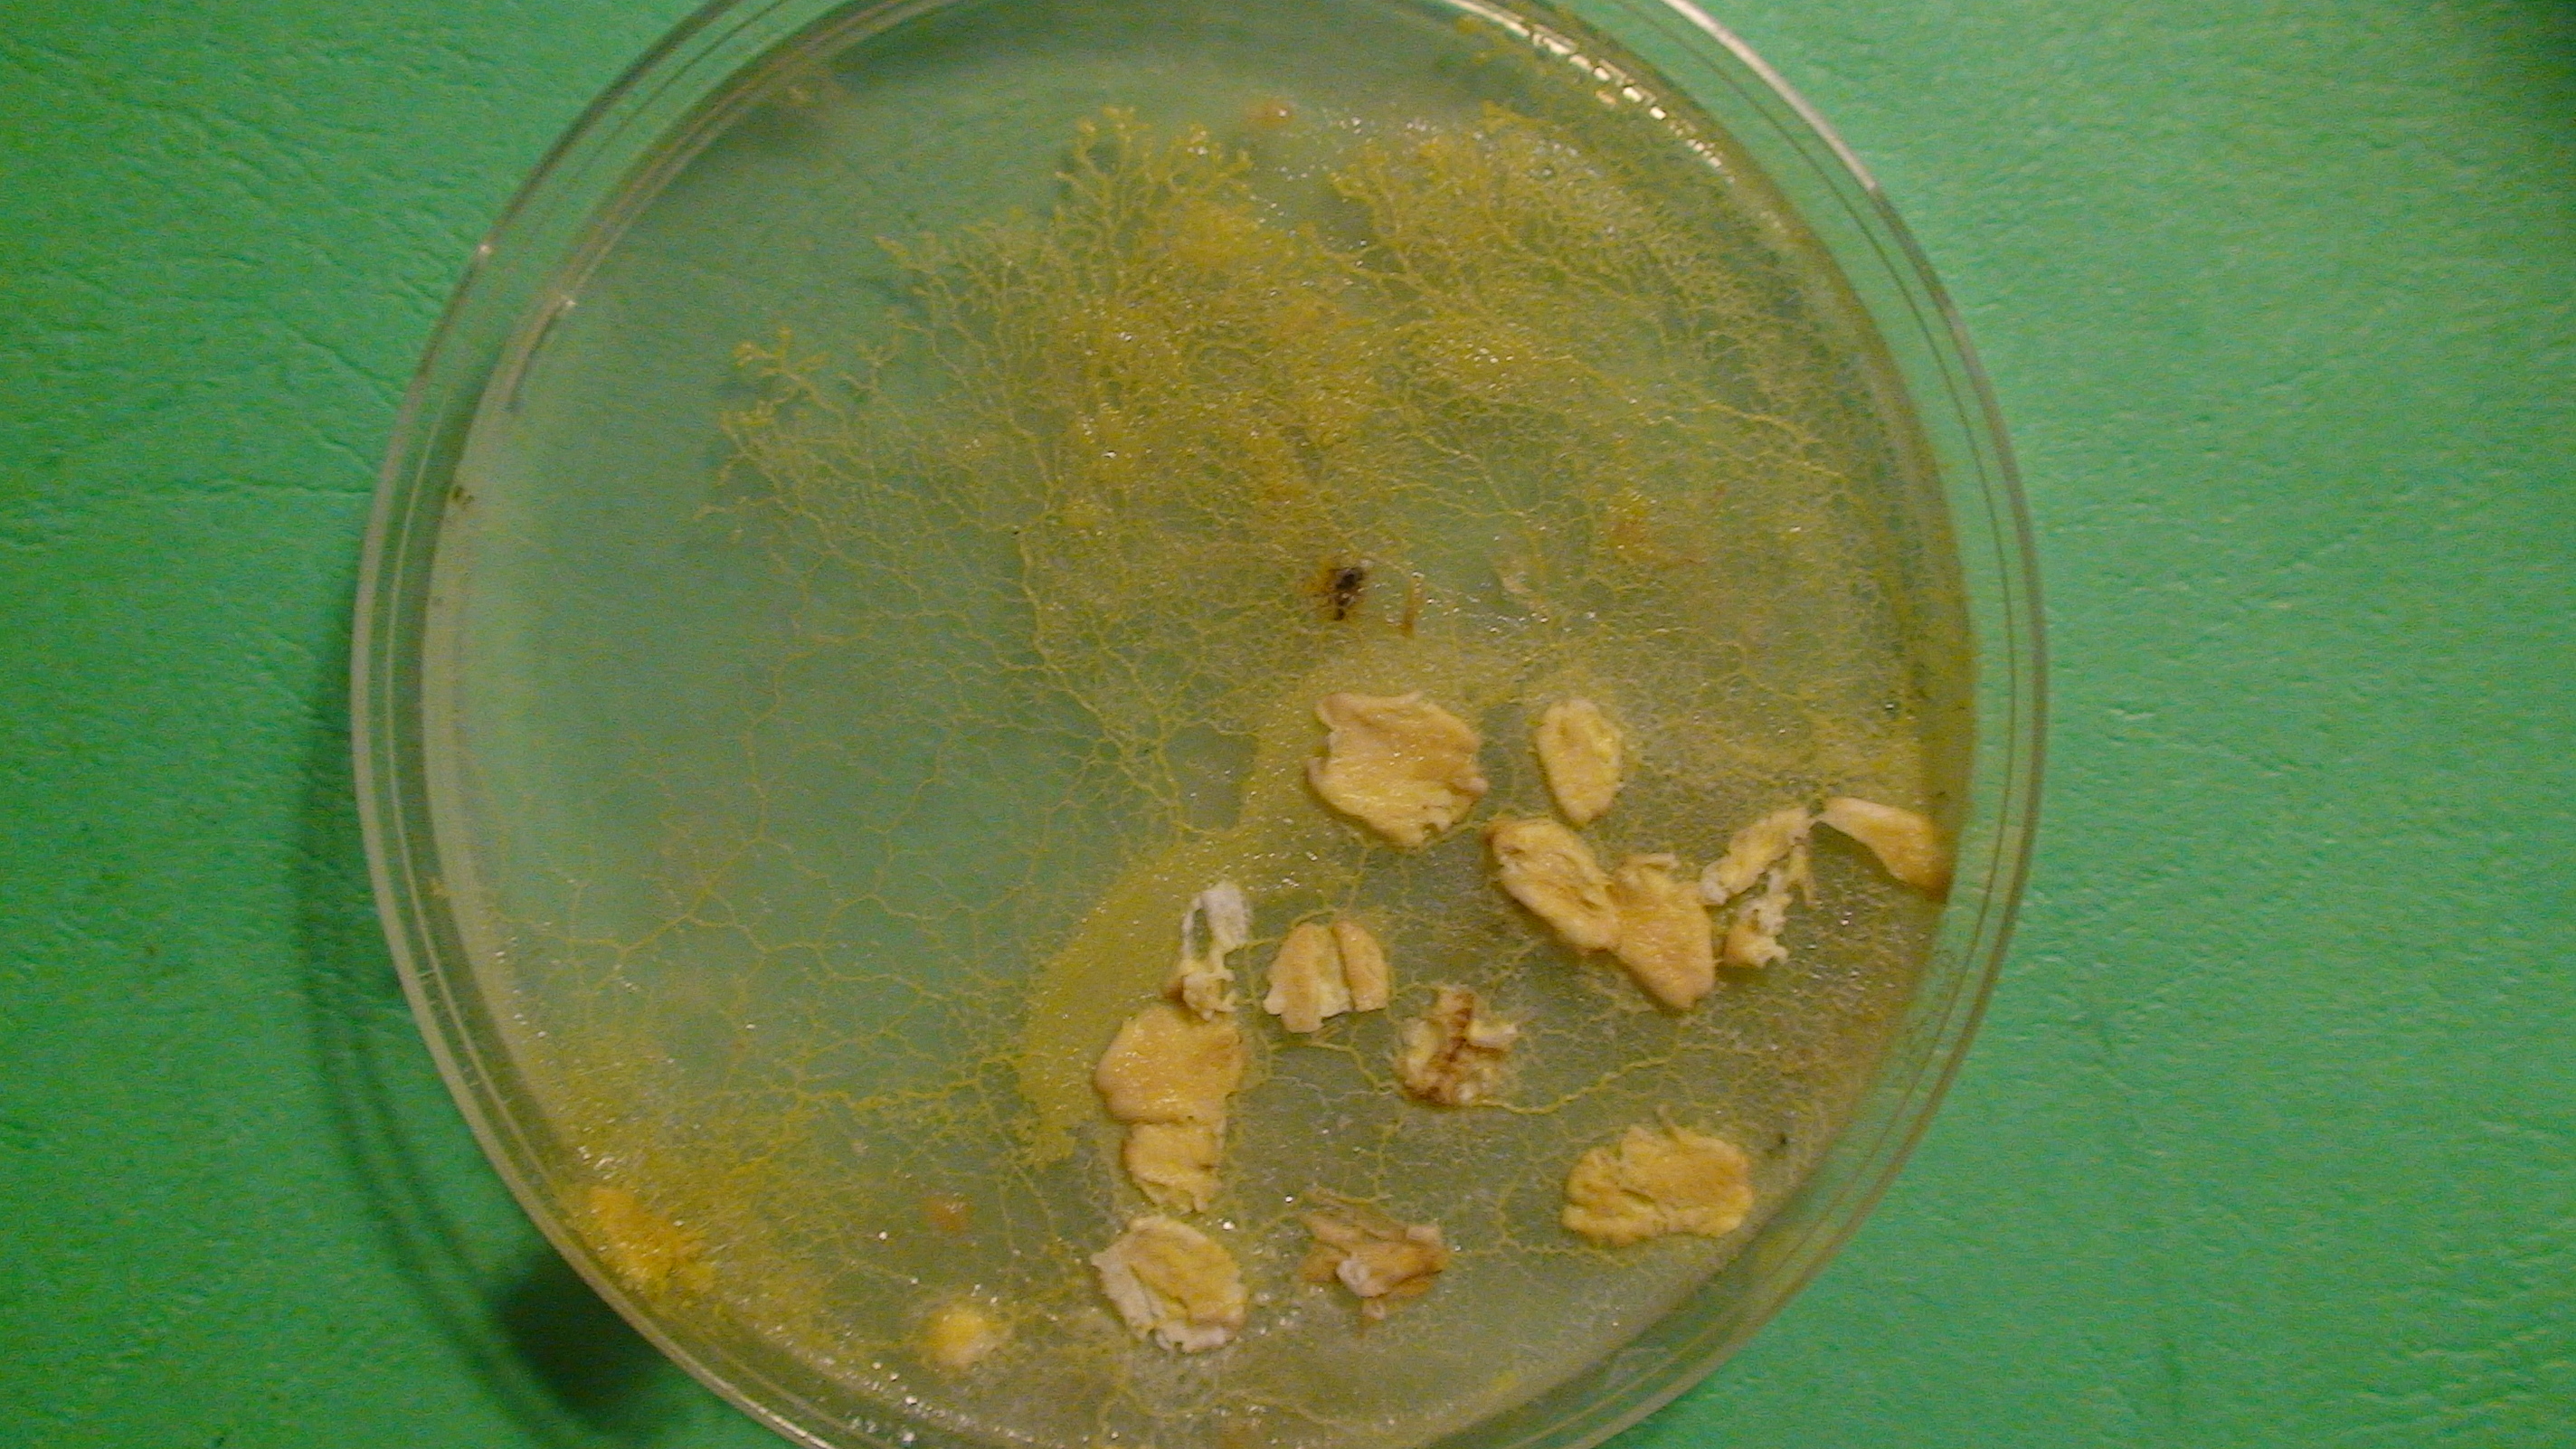

Physarum polycephalum
These “Plasmodium” slime molds are actually a network of individual cells that fuse together to form these miniature “bags” of cytoplasm…that swarm and/or “channel” themselves as they search for material to surround and consume. In the case of the slime mold specimens at the MassGlobalMegaCorp Laboratories, we feed them unprocessed oats because it helps lower cholesterol.
Visual and hands-on learners will appreciate the wide spectrum of observable differences in the “branching shapes” of individual cultures; these small veins or channels of cytoplasm are a small testament to nature’s artistry. The shape of their branching, in addition to their ability to breakdown matter using their own built-in chemistry set of enzymes gives students the opportunity to learn about the tools used by organisms to set the process of decomposition into motion.